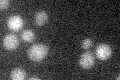
YBL034C

View description
Component of the mitotic spindle that binds to interpolar microtubules via its association with beta-tubulin (Tub2p); required for interpolar microtubules to provide an outward force on the spindle poles
Localization:
Intensity:
Fold change:
Significance:
-
C’ GFP library in SD

punctate17.35 -
N' NOP1pr-GFP in SD

punctate,nucleus65.7331 -
N' TEF2pr-mCherry in SD

punctate75.324 -
N' NATIVEpr-GFP in SD

punctate19.3892 -
N' TEF2pr-VC and Cyto-VN in SD

#N/A0 -
C’ GFP library in SD+DTT

punctate14.970.86No -
C’ GFP library in SD+H2O2

punctate19.361.11No -
C’ GFP library in Starvation Media
punctate18.081.04No -
C’ GFP library on the background of Pup2-DaMP

punctate -
C’ GFP library on the background of CCT mutant

punctate18.5411.06796No
